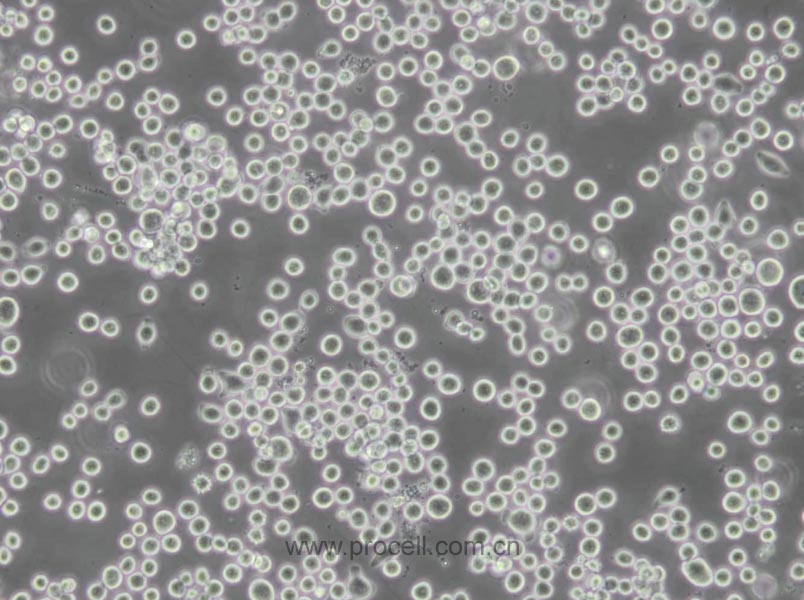
COLO 205 (人結腸癌細胞) (STR鑒定正確)
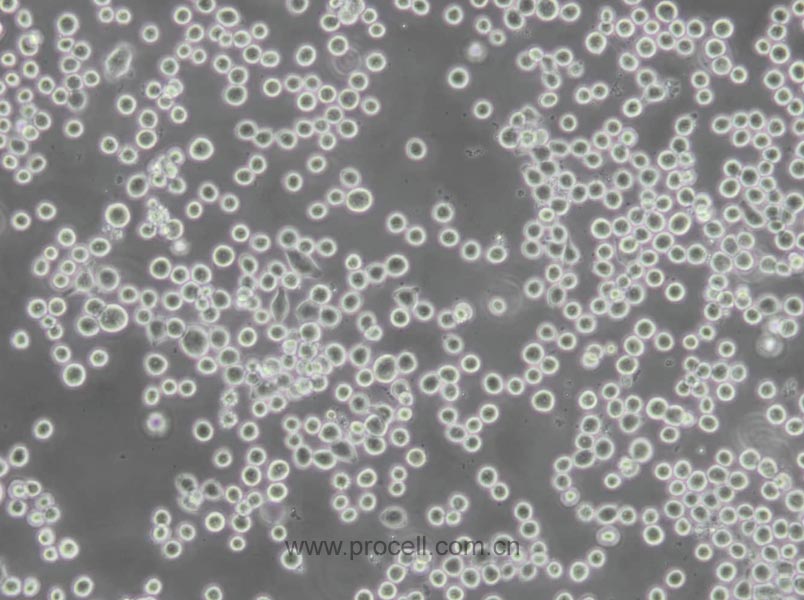
COLO 205 (人結腸癌細胞) (STR鑒定正確)
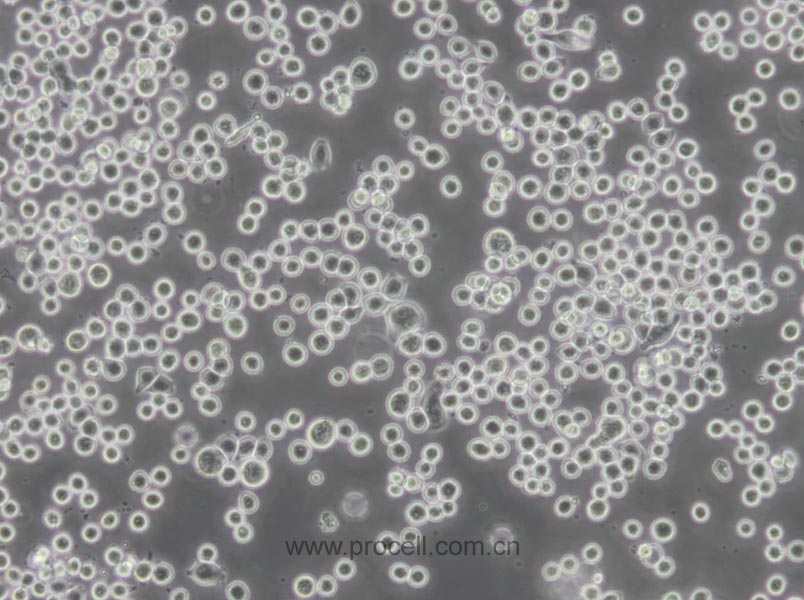
COLO 205 (人結腸癌細胞) (STR鑒定正確)

產(chǎn)品中心Cell Resources
聯(lián)系我們CONTACT US
400-999-210024小時服務熱線
產(chǎn)品概述
| 名稱 | COLO 205 (人結腸癌細胞) (STR鑒定正確) |
| 別稱 | Colo 205; CoLo 205; COLO-205; Colo-205; COLO.205; Colo205; COLO205; Co 205 |
| 種屬 | 人 |
| 生長特性 | 半貼半懸 |
| 細胞形態(tài) | 上皮細胞樣 |
| 凍存條件 | 凍存液:55% 基礎培養(yǎng)基+40%FBS+5%DMSO 溫度:液氮 |
| 培養(yǎng)方案A(默認) |
培養(yǎng)條件:
氣相:空氣,95%;CO2,5%, 溫度:37℃
|
| 推薦傳代比例 | 1:2-1:4 |
| 推薦換液頻率 | 2-3天/次 |
| 背景描述 | COLO 205細胞是由T·U·Sample等人于1957年從患有結腸癌的70歲男性白人的腹水分離而建系的,該病人在取腹水樣品前已用5-氟尿嘧啶治療4-6周;COLO 205細胞角蛋白免疫過氧化物酶染色陽性。 |
| 年齡(性別) | 男性;70歲 |
| 組織來源 | 結直腸腺癌,腹水轉移 |
| 細胞類型 | 腫瘤細胞 |
| 腫瘤類型 | 腸癌細胞 |
| 生物安全等級 | BSL-1 |
| 倍增時間 | ~25-30 hours |
| 致瘤性 | Yes, in nude mice (Tumors developed within 21 days at 100% frequency (5/5) in nude mice inoculated subcutaneously with 1×10^7 cells). |
| 基因表達情況 | carcinoembryonic antigen (CEA) 1.5 to 4.1 ng/10^6 cells cells/10 days; keratin; interleukin 10 (IL-10, interleukin-10), The cells are positive for keratin by immunoperoxidase staining. |
| 保藏機構 | ATCC; CCL-222 BCRC; 60054 ECACC; 87061208 |
STR鑒定
-
STR位點信息
Amelogenin X CSF1PO 11,12 D2S1338 17,18 D3S1358 16 D5S818 10,13 D7S820 9,10 D8S1179 9,14 D13S317 10,12 D16S539 12,13 D18S51 18 D19S433 13,14 D21S11 30.2,33.2 FGA 21,23 PentaD 9,11 PentaE 13,15 TH01 8,9 TPOX 11 vWA 15 D6S1043 11 D12S391 15 D2S441 10,11 -
STR鑒定圖
-
參考文獻
-
Raltitrexed as a synergistic hyperthermia chemotherapy drug screened in patient-derived colorectal cancer organoids(2021/8/15)
作者:Lisi Zeng, Quanxing Liao, Haoran Zhao
期刊:Cancer Biology & Medicine
DOI:10.20892/j.issn.2095-3941.2020.0566
影響因子 :5.500
-
Long non-coding RNA HOXA-AS3 facilitates the malignancy in colorectal cancer by miR-4319/SPNS2 axis(2021/10/21)
作者:Yang Jiang, Xiaoyu Yu, Huixin Sun
期刊:Journal Of Physiology And Biochemistry
DOI:10.1007/s13105-021-00832-x
影響因子 :5.080
-
Integrating TCGA and single-cell sequencing data for colorectal cancer: a 10-gene prognostic risk assessment model(2023/09/13)
作者:Di Lu, Xiaofang Li, Yuan Yuan
期刊:Discover Oncology
DOI:10.1007/s12672-023-00789-x
影響因子 :2.200
引用產(chǎn)品:CL-0066
FAQs
Q:{{item.question}}
A:
產(chǎn)品資料
識別碼示意圖

![A-204 [A204] (人橫紋肌肉瘤細胞)(STR鑒定正確)](/Public/upfile/pic/xbx/CL-0475-1.jpg)













